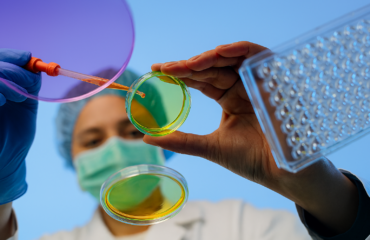

farmárstvo Bc.
chov zvierat, pestovanie plodín
Klikni na kategóriu, ktorá ťa zaujíma a nájdeš ponuku bakalárskych študijných programov, ktoré zodpovedajú tvojim záujmom.

chov zvierat, pestovanie plodín

chov zvierat

ekológia, klimatická zmena, pestovanie plodín

chov zvierat

chov zvierat

potraviny a výživa

chov zvierat, pestovanie plodín

biológia

potraviny a výživa

ekonómia a manažment

ekonómia a manažment, IT a programovanie, marketing, podnikanie a obchod, politiky EÚ, účtovníctvo

ekonómia a manažment, podnikanie a obchod

ekonómia a manažment, podnikanie a obchod

ekonómia a manažment, marketing, podnikanie a obchod

ekonómia a manažment, podnikanie a obchod, účtovníctvo

ekonómia a manažment, politiky EÚ, rozvoj regiónov

ekológia, klimatická zmena, krajina

architektúra, klimatická zmena, krajina

ekológia, pestovanie plodín, záhradníctvo

automobily, technika a strojárstvo

technika a strojárstvo

podnikanie a obchod, technika a strojárstvo

IT a programovanie, technika a strojárstvo

agroturizmus, ekonómia a manažment, rozvoj regiónov, samospráva

potraviny a výživa
biotechnológie